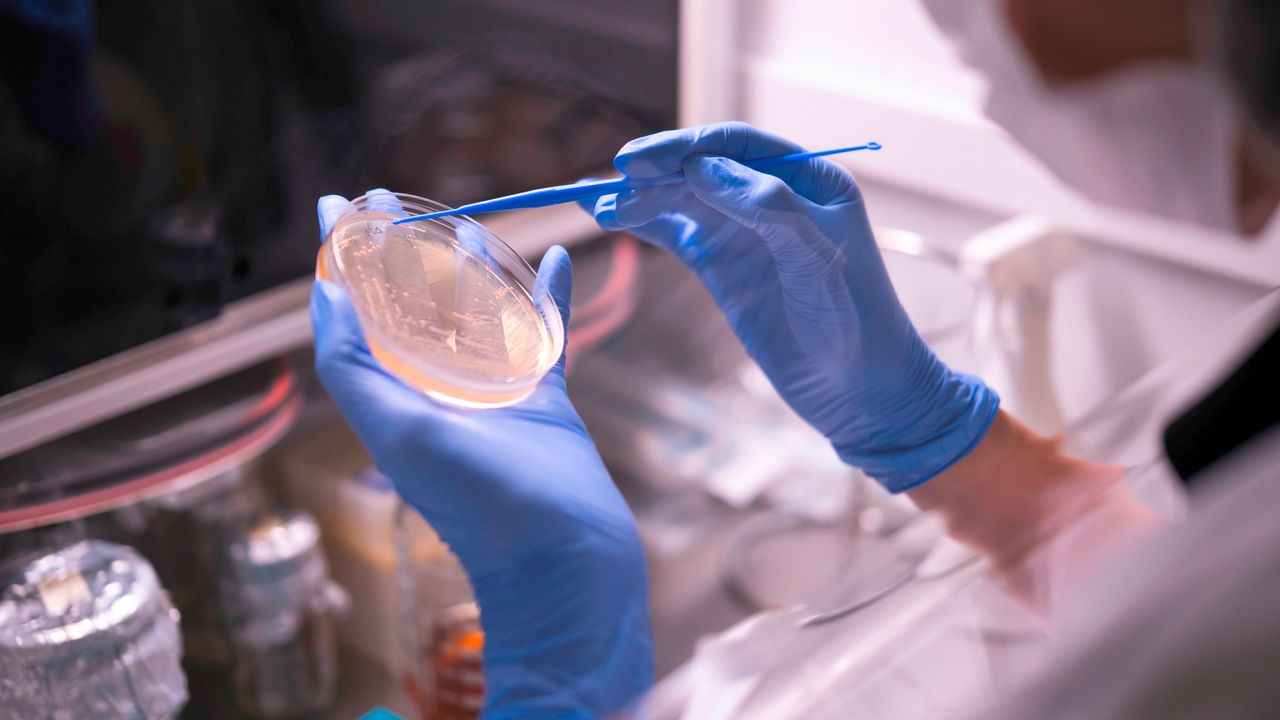

Orzaks’ın üretim faaliyetlerini üstlenen stratejik merkez Nuvita İlaç, yaptığı yatırımlarla Türkiye’nin en fazla Ar-Ge harcaması yapan 250 şirketinden biri oldu. Ekonomi ve iş dünyası platformu Turkishtime tarafından her yıl hazırlanan “Türkiye Ar-Ge 250 Araştırması”nın 2024 sonuçları açıklandı.
Türkiye ihracatında ilk 500’e giren firmalar, Sanayi ve Teknoloji Bakanlığı’na kayıtlı Ar-Ge merkezleri bulunan şirketler ve Kamu Aydınlatma Platformu verilerini paylaşan firmaların katılımıyla ortaya çıkan listede, Orzaks’ın üretim gücü Nuvita İlaç, bu yılki performansıyla ilk 250’ye girmeyi başardı.
Bilime dayalı yaklaşımı, kalite odaklı üretim anlayışı ve uluslararası standartlara uygun üretim yapısıyla dikkat çeken Nuvita İlaç, geçtiğimiz yıl ilk 500 arasında yer alırken, Ar-Ge yatırımlarındaki yükselişle bu yıl ilk 250’ye tırmandı.
Nuvita İlaç, Ar-Ge harcamalarını 4 yılda 10 kat artırdı
Orzaks’ın üretim şirketi Nuvita İlaç, 2021’den bu yana Ar-Ge bütçesini 10 kat büyüttü. Bugün toplamda 100 milyon TL’yi aşan yatırımlarıyla inovasyona verdiği önemi ortaya koyan şirket, Ar-Ge merkezinde 38 projeyi eş zamanlı yürütüyor. Şimdiye kadar 9 kamu projesi başarıyla tamamlanırken, 2 projenin geliştirme çalışmaları devam ediyor. Ayrıca şirket, 2023’te 2, 2024’te ise 9 olmak üzere toplam 11 patent başvurusunda bulundu.
“İnsan sağlığına katkı sağlayacak çözümler üretiyoruz”
Turkishtime araştırmasına ilişkin değerlendirmelerde bulunan Nuvita İlaç Ar-Ge Müdürü Akif Kavak, şirketin sürdürülebilir büyümesi ve ülke ekonomisine katkısı açısından Ar-Ge’nin kritik rolüne dikkat çekti. Kavak şunları söyledi:

“Ar-Ge ve inovasyon yatırımlarımız yalnızca şirketimizin gelişimine değil, aynı zamanda ülkemizin kalkınma hedeflerine de hizmet ediyor. Bilimsel bilgiyi ekonomik değere dönüştürerek hem akademiye hem de özel sektöre katkı sağlıyoruz. Orzaks’ın üretim faaliyetlerini de yürüttüğü Ar-Ge merkezimizde inovatif projeler ve patent çalışmalarımızla sektöre kalıcı değerler kazandırıyoruz. Özellikle stratejik hammaddelerin üretimine yönelik projelerimizle ülkemizin ihtiyaçlarını karşılamanın yanı sıra, insan sağlığına fayda sağlayacak yenilikçi çözümler geliştirmeye devam edeceğiz.”